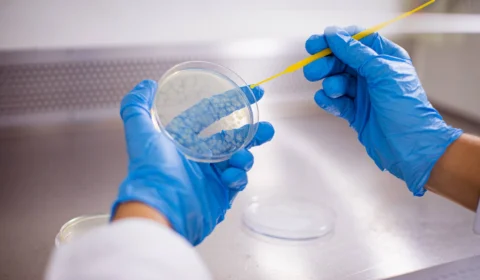
Comissão aprova PLP que impede corte de despesas com bolsas de pesquisa

Prouni: mais de 240 mil bolsas serão ofertadas; saiba mais
Inscrições abrem de 23 a 26 de julho para o segundo semestre. Bolsas serão distribuídas em 367 cursos e 901 instituições em todo o Brasil.
Comissão aprova PLP que impede corte de despesas com bolsas de pesquisa
Projeto de lei que impede a limitação de despesas com bolsas de estudo, pesquisa e auxílios em instituições de ensino é aprovado na Comissão de Educação do Senado
14 instituições em Manaus se credenciam para Programa Bolsa Universidade 2023
Quatorze instituições de ensino superior em Manaus participarão do processo seletivo do Programa Bolsa Universidade, com bolsas integrais e parciais disponíveis.
Inscrição para Olimpíada Virtual de História pode ser feita até 14 de outubro
Olimpíada Nacional em História do Brasil Aberta para Todos está com inscrições abertas até 14 de outubro, com 400 bolsas de R$ 100 mensais para escolas públicas
Prorrogação: informações do Prouni devem ser comprovadas até 14 de outubro
MEC prorroga prazo para comprovação de informações da lista de espera do Prouni até 14 de outubro
Prazo para se inscrever na lista de espera do Prouni termina nesta quarta-feira
Prouni encerra inscrições na lista de espera nesta quarta-feira (28), e resultado será divulgado no dia 3 de outubro.
Inscrições do Prouni para o segundo semestre terminam nesta sexta-feira
Inscrições para o Programa Universidade para Todos (ProUni) vão até 5 de agosto; resultado da primeira chamada sai no dia 9 de agosto.
Prazo para instituições aderirem ao ProUni termina nesta sexta-feira
ProUni está com inscrições abertas até esta sexta-feira, 22, e oferece bolsas de estudo para estudantes de baixa renda e professores da rede pública.
Inscrições para bolsas de estudo da Capes terminam na próxima quarta-feira (27/07)
Capes oferece 60 bolsas de doutorado e pós-doutorado para projetos que busquem melhorar as condições de vida após desastres ambientais.
Profissionais da saúde: instituições podem fazer cadastro para Exame Nacional de Residência
Instituições de saúde podem aderir à edição 2022/2023 do Exame Nacional de Residência (Enare) a partir desta quarta-feira, 20, até 2 de agosto.